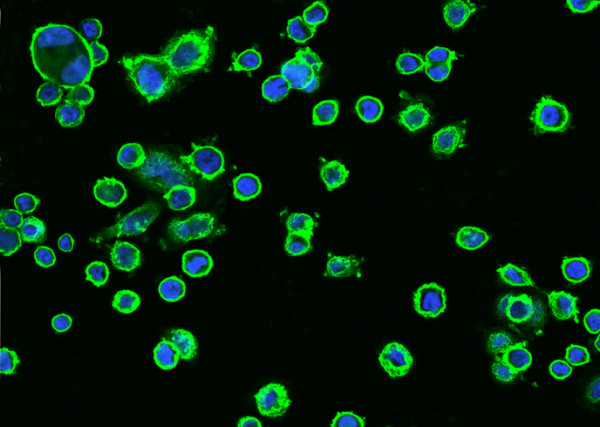
Anti-HER2/ErbB2/CD340 Monoclonal Recombinant Antibody

Cookie preferences
This website uses cookies, which are necessary for the technical operation of the website and are always set. Other cookies, which increase the comfort when using this website, are used for direct advertising or to facilitate interaction with other websites and social networks, are only set with your consent.
Configuration
Technically required
These cookies are necessary for the basic functions of the shop.
"Allow all cookies" cookie
"Decline all cookies" cookie
CSRF token
Cookie preferences
Currency change
Customer-specific caching
FACT-Finder tracking
Individual prices
Selected shop
Session
Comfort functions
These cookies are used to make the shopping experience even more appealing, for example for the recognition of the visitor.
Note
Show the facebook fanpage in the right blod sidebar
Statistics & Tracking
Affiliate program
Conversion and usertracking via Google Tag Manager
Track device being used
| Item number | Size | Datasheet | Manual | SDS | Delivery time | Quantity | Price |
|---|---|---|---|---|---|---|---|
| E-AN300004P.20 | 20 µl | - |
7 - 16 business days* |
182.00€
|
|||
| E-AN300004P.100 | 100 µl | - |
7 - 16 business days* |
462.00€
|
If you have any questions, please use our Contact Form.
You can also order by e-mail: info@biomol.com
Larger quantity required? Request bulk
You can also order by e-mail: info@biomol.com
Larger quantity required? Request bulk
ErbB2, also called Neu and Her2, is a transmembrane glycoprotein in the ErbB family of tyrosine... more
Product information "Anti-HER2/ErbB2/CD340 Monoclonal Recombinant Antibody"
ErbB2, also called Neu and Her2, is a transmembrane glycoprotein in the ErbB family of tyrosine kinase receptors for EGF superfamily growth factors. ErbB2 is widely expressed in epithelial cells and over-expressed in a large number of breast carcinomas. ErbB2 has no identified ligands but heterodimerizes with ErbB1/EGF R, ErbB3, or ErbB4 to form higher affinity signaling complexes. The protease ADAM10 releases a 110 kDa soluble fragment of ErbB2 from the cell surface. ErbB2 plays roles in development, cancer, communication at the neuromuscular junction, and regulation of cell growth and differentiation. The ErbB2/ErbB3 heterodimer is expressed in the majority of breast, skin, ovary and gastrointestinal tumors and transduces a highly mitogenic signal in response to neuregulin 1 (NRG1, heuregulin 1) or NRG2. ErbB3, ErbB2 and neuregulin are all required for formation of the sympathetic nervous system. Protein function: Protein tyrosine kinase that is part of several cell surface receptor complexes, but that apparently needs a coreceptor for ligand binding. Essential component of a neuregulin-receptor complex, although neuregulins do not interact with it alone. GP30 is a potential ligand for this receptor. Regulates outgrowth and stabilization of peripheral microtubules (MTs). Upon ERBB2 activation, the MEMO1-RHOA-DIAPH1 signaling pathway elicits the phosphorylation and thus the inhibition of GSK3B at cell membrane. This prevents the phosphorylation of APC and CLASP2, allowing its association with the cell membrane. In turn, membrane-bound APC allows the localization of MACF1 to the cell membrane, which is required for microtubule capture and stabilization. [The UniProt Consortium]
| Keywords: | HER2, CD340, ERBB2, MLN 19, p185erbB2, EC=2.7.10.1, Proto-oncogene Neu, Proto-oncogene c-ErbB-2, Metastatic lymph node gene 19 protein, Receptor tyrosine-protein kinase erbB-2, Tyrosine kinase-type cell surface receptor HER2, Recombinant HER2/ErbB2/CD340 |
| Supplier: | Elabscience |
| Supplier-Nr: | E-AN300004P |
Properties
| Application: | IHC (paraffin), FCM, ICC/IF |
| Antibody Type: | Monoclonal |
| Clone: | 1A8 |
| Conjugate: | No |
| Host: | Rabbit |
| Species reactivity: | human |
| Immunogen: | Recombinant Human HER2/ErbB2/CD340 Protein |
| Format: | Purified |
Database Information
| KEGG ID : | K05083 | Matching products |
| UniProt ID : | P04626 | Matching products |
| Gene ID : | GeneID 2064 | Matching products |
Handling & Safety
| Storage: | +4°C (avoid repeat freezing and thawing cycles) |
| Shipping: | +4°C (International: +4°C) |
| Signal Word: | Warning |
| GHS Hazard Pictograms: |
|
| H Phrases: | H317 |
| P Phrases: | P261, P272, P280, P302+352, P333+313 |
Caution
Our products are for laboratory research use only: Not for administration to humans!
Our products are for laboratory research use only: Not for administration to humans!
Information about the product reference will follow.
more
You will get a certificate here
Viewed